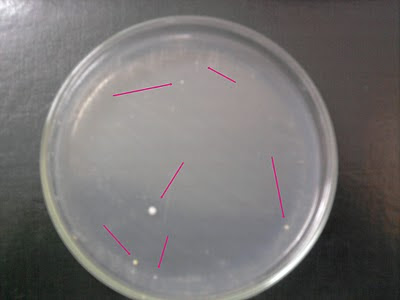

Meu pai morreu.
Eu tenho um pouco de resistência com a palavra "falecer" porque você enfeita uma situação e isso não a torna menos pior. Ele morreu, ponto. Verbo intransitivo. É como no velório onde as pessoas chegavam até mim e diziam: "meus sentimentos". Ok. Que sentimentos? Bons? Ruins?
Se tem algo que eu posso aconselhar que você faça quando alguém que você ama muito morra é: se ocupe! Resolva as coisas, aja, tome providências e continue vivendo. Porque você não morreu, sabe? É assim que me sinto. Eu não morri e, com certeza, meu pai tiraria satisfações comigo de porquê eu não estou fazendo alguma coisa ou estou deixando os outros decidirem tudo por mim. Ele sempre fez muita questão de que eu soubesse fazer de tudo, desde dirigir até resolver coisas de banco. Acho que ele sempre quis me preparar pra esta situação.
Então, que quando alguém morre existem milhões de coisas a serem resolvidas. E algumas delas são fáceis e outras, bem... nem tanto. Mexer nas coisas dele, nas roupas e nos documentos... aí eu encontro algo que só faz sentido no mundo dele e no meu e aquilo é uma forte lembrança de que esses momentos de "criar momentos" não vão acontecer mais... As lembrancinhas da missa de sétimo dia que ficaram prontas, meu padrinho que veio checar como eu estava, meus avós chorando... são coisas difíceis.
Porém, cada vez que me deparo com uma situação em que preciso tomar uma decisão eu tenho certeza de que ele me ensinou tudo o que eu precisava saber. São pequenas coisas e grandes coisas: a farinha de trigo guardada meio escondida caso minha vó usasse tudo ainda teria uma de reserva, a segunda via original da certidão de nascimento da minha irmã, sua obsessão louca em pagar seguros e o tanto que ele lutou para que eu e respectivo continuassemos juntos e bem.
Não há preparo pra este tipo de experiência e não há alívio pra dor. Mas existe esperança, existe conforto e existe um dia depois do outro pra dar força e pra se aprender a viver essa vida diferente. Está tudo igual mas ao mesmo tempo tudo está diferente.
Meu pai cumpriu todas as promessas que me fez durante a minha vida inclusive a de que nunca me deixaria até que eu estivesse pronta pra isso...
Obrigada pai, amo você pra sempre.